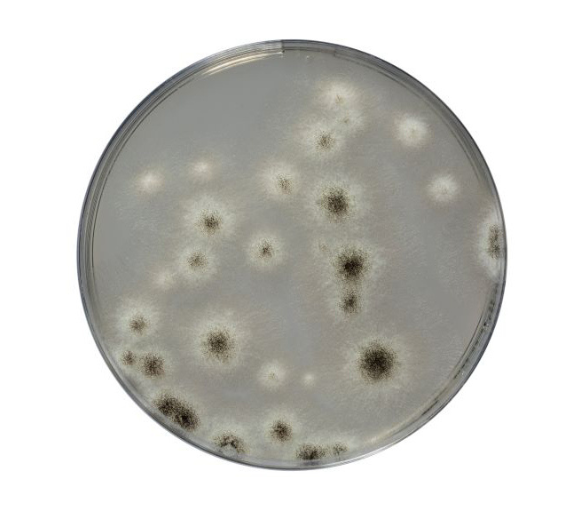
sabouraud-dextrose

Sabouraud Dextrose chloramphenicol Agar (SDCA) được khuyến cáo để phân lập và định lượng nấm men và nấm mốc, đặc biệt khi các mẫu bị nhiễm vi khuẩn cao. Nó cũng được sử dụng làm môi trường phân lập chọn lọc cho Candida albicans trong các sản phẩm mỹ phẩm.
Thành phần môi trường theo NF EN ISO 18416 và NF EN ISO 16212.
NGUYÊN TẮC:
Peptic digest of Meat là nguồn nitơ cho sự phát triển.
Glucose là một nguồn năng lượng.
Chloramphenicol là một loại kháng sinh phổ rộng, bền với nhiệt, ức chế sự phát triển của hệ vi sinh gây tạp nhiễm.


 English
English